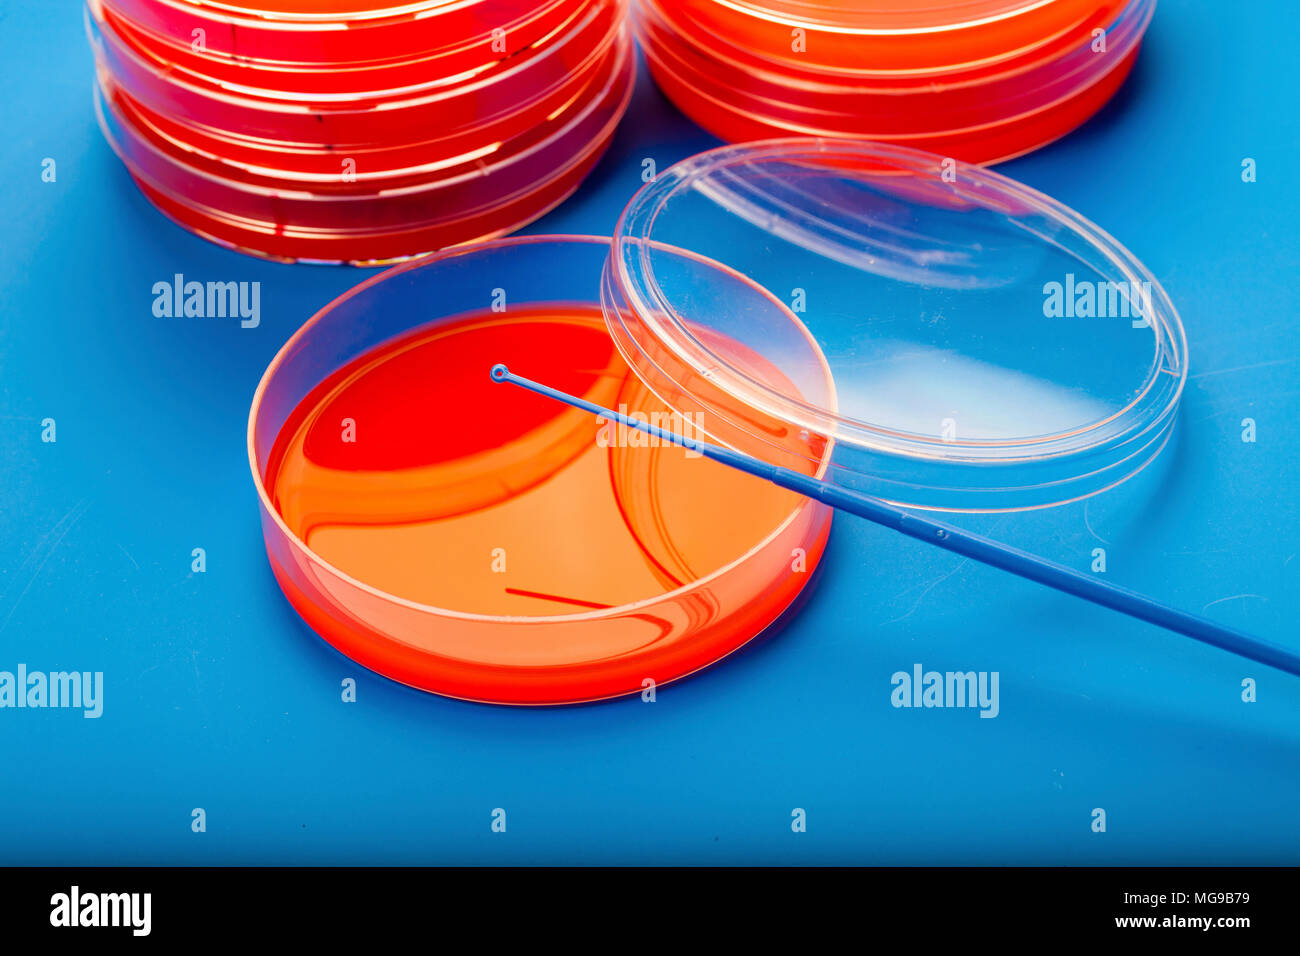
Petrischalen mit Blut Agar. Stockfoto

Petrischalen mit Blut Agar.
RFID:Bild-ID:MG9B79
Bilddetails
Bildanbieter:
Science Photo LibraryBild-ID:
MG9B79Dateigröße:
60,2 MB (1,9 MB Komprimierter Download)Freigaben (Releases):
Model - nein | Eigentum - neinBenötige ich eine Freigabe?Format:
5616 x 3744 px | 47,5 x 31,7 cm | 18,7 x 12,5 inches | 300dpiAufnahmedatum:
26. April 2018